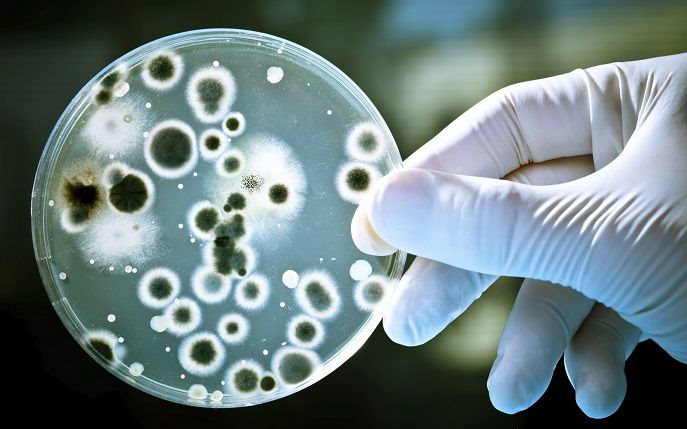

研究发现火星上可能已经有生命,而且活着的时间远超我们的想象!
就我们所知,火星不是一个生命友善的地方。 虽然赤道地区的气温在夏天的中午可以高达35°C(95°F),但表面平均温度为-63°C(-82°F),在极地的冬天最低温度可达 -143°C(-226°F)。 它的大气压力约为地球的百分之一的一半,表面暴露于相当大的辐射。

到现在为止,没有人确定微生物能否在这种极端的环境中生存。 但是感谢莫斯科国立大学(LMSU)的一个研究小组的新研究,我们现在知道微生物能够承受什么样的环境条件。 因此,这项研究可能对寻找太阳系其他地方的生命有重大的意义,甚至可能超越!
这研究标题为“模拟火星条件下古北极冻土层内被100 kGy伽马辐射影响的微生物群”(100 ;kGy gamma-affected microbial communities within the ancient Arctic permafrost under simulated Martian conditions) ,最近出现在科学期刊“极端微生物”(Extremophiles)中。 由LMSU的Vladimir S. Cheptsov领导的研究小组包括来自俄罗斯科学院,圣彼得堡国立工业大学,库尔恰托夫研究所和乌拉尔联邦大学的成员。
为了研究的目的,研究小组假设温度和压力条件不会是决定因素,而是辐射。 因此,他们进行了模拟火星土里的微生物群被辐射照射的测试。 模拟的风化石含有冻土的沉积岩,然后经受低温和低压的条件之下。

为了模拟火星的条件,团队使用了一个原创的恒温气候室,保持了低温和大气压力。 然后他们将微生物暴露在不同程度的伽玛辐射中。 他们发现,在模拟的火星环境中,微生物群对温度和压力条件表现出高度的抵抗力。
不过,当他们开始照射微生物后,发现被照射样本和控制样本之间存在一些差异。 原核细胞的总数量和代谢活性细菌的数量在控制的清况下保持不变,被辐射照射的细菌数量减少了两个数量级,而古细菌代谢活性细胞的数量减少了三倍。
研究小组还注意到,在多年冻土被照射的样本中,细菌的生物多样性很高,而且这种细菌经过辐射照射后发生了明显的结构变化。 例如,放线菌群(Arthrobacter,一种在土壤中常见的细菌)不存在于控制样本中,而是在被照射的细菌群中变成占多数。
简单说,这些结果表明,火星上的微生物比以前想象的更俱生存力。 它们除了能够承受寒冷的气候和低气压之外,还能够存活于火星表面上常见的各种辐射条件。

这项研究因为很多原因而非常重大。 一方面,作者首次证明原核生物细菌能够在超过80kGy的辐射下存活,这在以前被认为是不可能的。 他们还证明,尽管条件严苛,微生物仍然可以在今天的火星上生存,活在永久冻土和土壤中。
这项研究还表明,在考虑生物的生存条件时,外星生命和宇宙因素有很大的重要性。 最后,这项研究已经做了一些以前没有研究过的东西,这就是对火星上特别是在风化层和不同深度的微生物定出一个抗辐射的限度。

这些资料对未来太阳系、火星和其他地点的任务,甚至是对系外行星的研究都是非常宝贵的。 了解生命能发展的条件将有助于我们确定去哪里寻找它的迹象。 而在准备任务时,科学家也可以知道要避开什么地方,以防止污染土著生态系统。

发表你的评论吧返回顶部
!评论内容需包含中文
